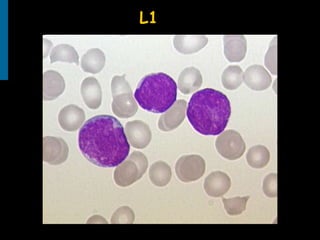
L1
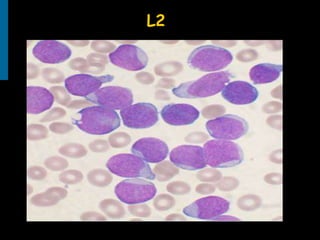
L2

Acute lymphoblastic leukemia (ALL) is the most common childhood leukemia, accounting for 80% of cases. It is a cancer of the lymphoid cells of the bone marrow. Patients present with fatigue, fever, and bleeding due to bone marrow failure. Diagnosis involves blood tests showing reduced blood counts and blast cells in the bone marrow. Treatment involves remission induction, intensification, and maintenance therapy, with an overall cure rate of around 85%. Prognosis depends on factors like age, genetics, and response to initial treatment.